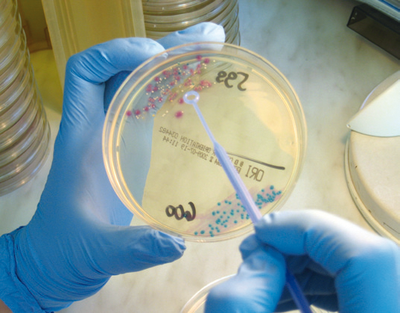

Doc aktuell PR-Anzeige
LIEBE IST AUCH VERANTWORTUNG

In den warmen Monaten ist für viele Menschen die beste Zeit, um sich neu zu verlieben. Doch trotz der Schmetterlinge im Bauch hat man vielleicht vor dem Eingehen einer neuen sexuellen Beziehung noch einige Bedenken: „Bin ich selbst oder mein neuer Partner frei von sexuell übertragbaren Krankheiten (STD)?” Durch das offene Gespräch mit dem Partner sollte man Risiken abklären. Wie war das Vorleben des neuen Partners? Wie wollen wir uns schützen? Verheimlichen nützt letztlich nur den Infektionserregern etwas.
Experten und Gesundheitsbehörden in ganz Europa, insbesondere in Osteuropa, stellen eine Zunahme der „klassischen Geschlechtskrankheiten“ fest, da in der Bevölkerung der Glaube vorherrscht, dass diese praktisch verschwunden seien und sich somit Sorglosigkeit einstellt. Ein weiterer Irrglaube besteht darin, dass diese Infektionen in Deutschland nicht mehr vorkommen und nur als Reisesouvenirs aus dem Urlaub mitgebracht werden.
Oft verursachen die Erreger von sexuell übertragenen Infektionen nämlich lange Zeit keinerlei oder nur kaum merkliche Krankheitszeichen. Die Symptome können sehr unspezifisch sein und scheinen oftmals auf ganz andere Krankheiten hinzuweisen. Die Ansteckung erfolgt überwiegend beim Geschlechtsverkehr durch den direkten Kontakt von infizierten Körperflüssigkeiten mit Schleimhäuten. Eine Ansteckung kann aber auch von einer infizierten Mutter auf das ungeborene Kind erfolgen.
Unbehandelt haben die meisten sexuell übertragenen Krankheiten schwerwiegende Folgen. Chronische bakterielle Entzündungen der Geschlechtsorgane können zu Unfruchtbarkeit führen. Einige Erreger können bei chronischem Verlauf Krebserkrankungen auslösen und viele von ihnen erhöhen außerdem noch das Risiko, sich mit dem HI-Virus anzustecken oder dieses auf die Sexualpartner zu übertragen. HIV ist der Erreger, der heute am meisten gefürchteten sexuell übertragenen Erkrankung – AIDS. Gegen diese Krankheit gibt es weder ein heilendes Medikament noch eine Schutzimpfung.
Im Anfangsstadium lassen sich die meisten STD erfolgreich behandeln. Die durch Bakterien verursachten STD können durch konsequente Behandlung vollständig ausheilen. Nicht heilbar sind dagegen die meisten durch Viren hervorgerufenen Erkrankungen. Für einige STD gibt es Impfungen, um sich vor Ansteckung zu schützen. Eine frühzeitige Therapie kann aber auch bei den unheilbaren viralen STD ein Fortschreiten der Erkrankung verhindern oder zumindest verlangsamen. Je eher eine sexuell übertragbare Krankheit erkannt und behandelt wird, desto geringer ist das Risiko ernsthafter und nicht mehr zu heilender Schäden. Und selbstverständlich senkt eine frühe Behandlung das Risiko, andere Menschen anzustecken. Zu den in unseren Regionen wichtigen sexuell übertragbaren Krankheiten gehören folgende Infektionen:
• AIDS
• Syphilis (Lues)
• Hepatitis B
• Chlamydieninfektionen
• Gonorrhoe (Tripper)
• Mykoplasmen-Infektionen
Hat ein ungeschützter Geschlechtsverkehr – vor allem mit einem nicht vertrauten Partner – stattgefunden, sollte auch bei den geringsten Beschwerden ein Arzt aufgesucht werden. Aber auch vorher kann man etwas tun: Durch eine Blutuntersuchung können viele Geschlechtskrankheiten in der Regel sicher erkannt werden, gelegentlich ist auch ein bakteriologischer Abstrich erforderlich. Die Untersuchung empfiehlt sich gerade beim Eingehen neuer Lebenspartnerschaften für beide Partner.
Schmudlach-Oswald-
kettermann & Kollegen
Ellerried 5-7
19057 Schwerin
Telefon 0385 - 644 24 0
www.labor-schwerin.de